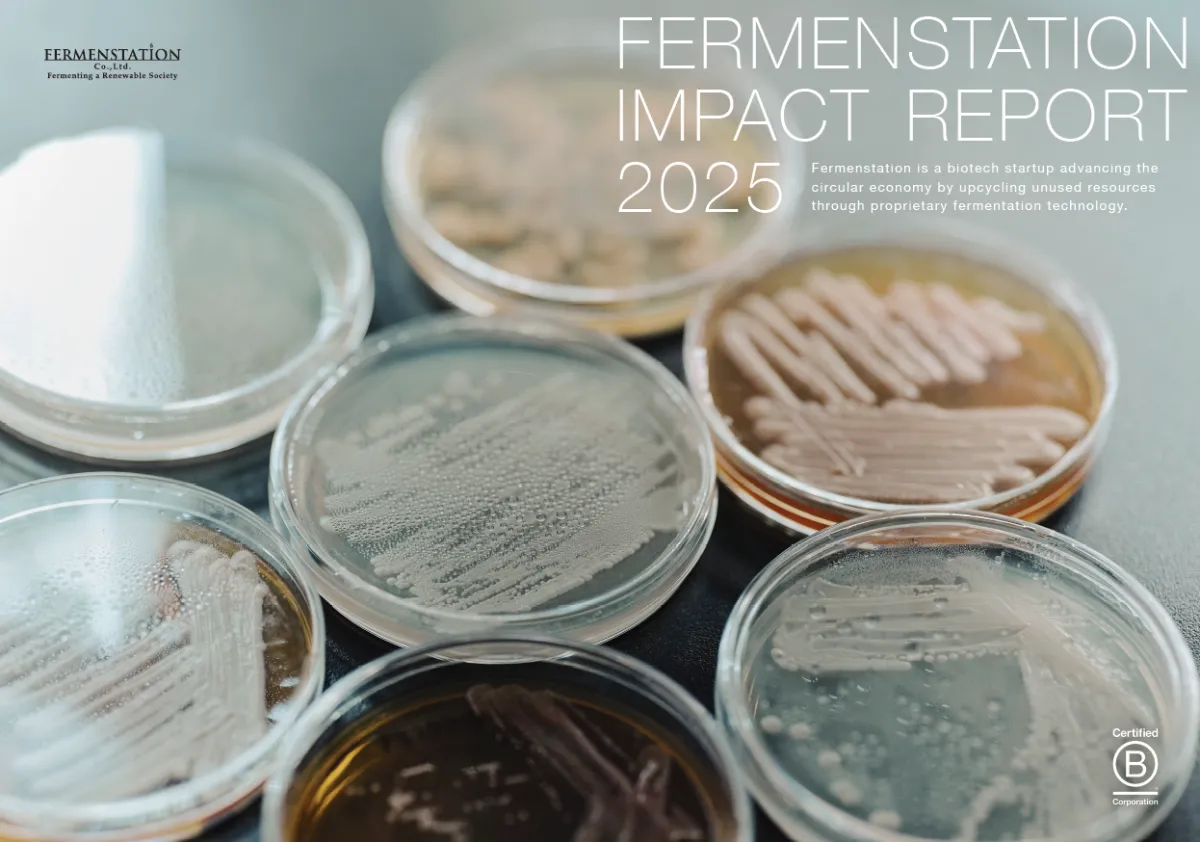

ファーメンステーションが示す未来への道筋とは?2025年度インパクトレポート公開
近年、持続可能な社会の実現に向けた様々な取り組みが世界中で進められています。その中でも注目を浴びているのが、株式会社ファーメンステーションです。このバイオものづくりスタートアップは、事業性と社会性の両立を目指す独自の発酵技術を駆使し、未利用資源を再生・循環させる社会の実現を目指しています。
2025年度版のインパクトレポートの発表は、同社のこれまでの活動を振り返り、未来への展望を示す重要な一歩です。本記事では、そのレポートの内容をご紹介し、ファーメンステーションがどのように持続可能な社会の構築に貢献しているのかを深掘りします。
ファーメンステーションは、創業以来、事業と社会的な価値の両方を追求してきました。2025年度のインパクトレポートでは、食領域への事業拡張について詳しく述べられています。食の課題に対処する中で遭遇した葛藤や試行錯誤のプロセスを開示し、より深いインパクトの創出に向けた取り組みを紹介しています。
レポートの中では、特に未利用資源から価値を生み出す挑戦として、ファーメンステーションがどのようにして社会性と事業性を両立させようとしているのかが強調されています。これにより、単なるビジネス成功にとどまらず、持続可能な資源循環型社会への道筋を示しています。
代表取締役の酒井里奈氏は、現在の社会状況に対する不安を認めつつも、ファーメンステーションの取り組みを通じて希望を失わずに進む姿勢を表明しました。「このレポートは、私たちが目指すインパクトとその過程における葛藤を記録したものです。読者からのご意見をいただければ幸いです。」と語っています。
食品ロスや未利用バイオマスの有効利用が、持続可能な未来に向けた重要なテーマであることは間違いありません。ファーメンステーションは、高度な発酵技術を用い、パートナー企業と連携して、食品製造過程で生じる副産物や食品残さを高付加価値な素材に変えていく事業共創を進めています。この取り組みは、アップサイクル素材を利用した新たな製品開発を促進し、食品ロスの解消に貢献します。
ファーメンステーションの強みはその技術にあります。未利用バイオマスを最大限活用するための独自のデータベースと発酵アップサイクル技術は、他では得られない高いクオリティのバイオ素材を生み出しています。また、同社は地域社会との連携も重視し、廃棄物を最小限に抑える循環型モデルを構築しています。
ファーメンステーションは、このような多面的な取り組みを背景に、国際的なB Corp認証も得ています。この認証は、経済、環境、社会において包括的な利益を生む企業に対して与えられるもので、同社の取り組みが高く評価されている証左です。これからも、持続可能なビジネスモデルを追求し、新しい価値を生み出す努力を続けていく意向を示しています。
株式会社ファーメンステーションは、未利用資源を活かして持続可能な社会を築くための新たな挑戦を続けています。2025年度インパクトレポートは、その挑戦の成果と、これからのビジョンを示す重要な資料です。今後の動向に注目するとともに、ぜひこのレポートを通じて、彼らの取り組みをチェックしてみてください。詳細は公式ウェブサイトやインパクトレポートからもご覧いただけます。


2025年度版のインパクトレポートの発表は、同社のこれまでの活動を振り返り、未来への展望を示す重要な一歩です。本記事では、そのレポートの内容をご紹介し、ファーメンステーションがどのように持続可能な社会の構築に貢献しているのかを深掘りします。
インパクトレポートの概要
ファーメンステーションは、創業以来、事業と社会的な価値の両方を追求してきました。2025年度のインパクトレポートでは、食領域への事業拡張について詳しく述べられています。食の課題に対処する中で遭遇した葛藤や試行錯誤のプロセスを開示し、より深いインパクトの創出に向けた取り組みを紹介しています。
レポートの中では、特に未利用資源から価値を生み出す挑戦として、ファーメンステーションがどのようにして社会性と事業性を両立させようとしているのかが強調されています。これにより、単なるビジネス成功にとどまらず、持続可能な資源循環型社会への道筋を示しています。
代表者の言葉
代表取締役の酒井里奈氏は、現在の社会状況に対する不安を認めつつも、ファーメンステーションの取り組みを通じて希望を失わずに進む姿勢を表明しました。「このレポートは、私たちが目指すインパクトとその過程における葛藤を記録したものです。読者からのご意見をいただければ幸いです。」と語っています。
食領域への事業拡張
食品ロスや未利用バイオマスの有効利用が、持続可能な未来に向けた重要なテーマであることは間違いありません。ファーメンステーションは、高度な発酵技術を用い、パートナー企業と連携して、食品製造過程で生じる副産物や食品残さを高付加価値な素材に変えていく事業共創を進めています。この取り組みは、アップサイクル素材を利用した新たな製品開発を促進し、食品ロスの解消に貢献します。
技術と事業共創
ファーメンステーションの強みはその技術にあります。未利用バイオマスを最大限活用するための独自のデータベースと発酵アップサイクル技術は、他では得られない高いクオリティのバイオ素材を生み出しています。また、同社は地域社会との連携も重視し、廃棄物を最小限に抑える循環型モデルを構築しています。
B Corp認証の取得
ファーメンステーションは、このような多面的な取り組みを背景に、国際的なB Corp認証も得ています。この認証は、経済、環境、社会において包括的な利益を生む企業に対して与えられるもので、同社の取り組みが高く評価されている証左です。これからも、持続可能なビジネスモデルを追求し、新しい価値を生み出す努力を続けていく意向を示しています。
まとめ
株式会社ファーメンステーションは、未利用資源を活かして持続可能な社会を築くための新たな挑戦を続けています。2025年度インパクトレポートは、その挑戦の成果と、これからのビジョンを示す重要な資料です。今後の動向に注目するとともに、ぜひこのレポートを通じて、彼らの取り組みをチェックしてみてください。詳細は公式ウェブサイトやインパクトレポートからもご覧いただけます。


関連リンク
サードペディア百科事典: 発酵技術 ファーメンステーション インパクトレポート
トピックス(ライフスタイル・カルチャー)










【記事の利用について】
タイトルと記事文章は、記事のあるページにリンクを張っていただければ、無料で利用できます。
※画像は、利用できませんのでご注意ください。
【リンクついて】
リンクフリーです。